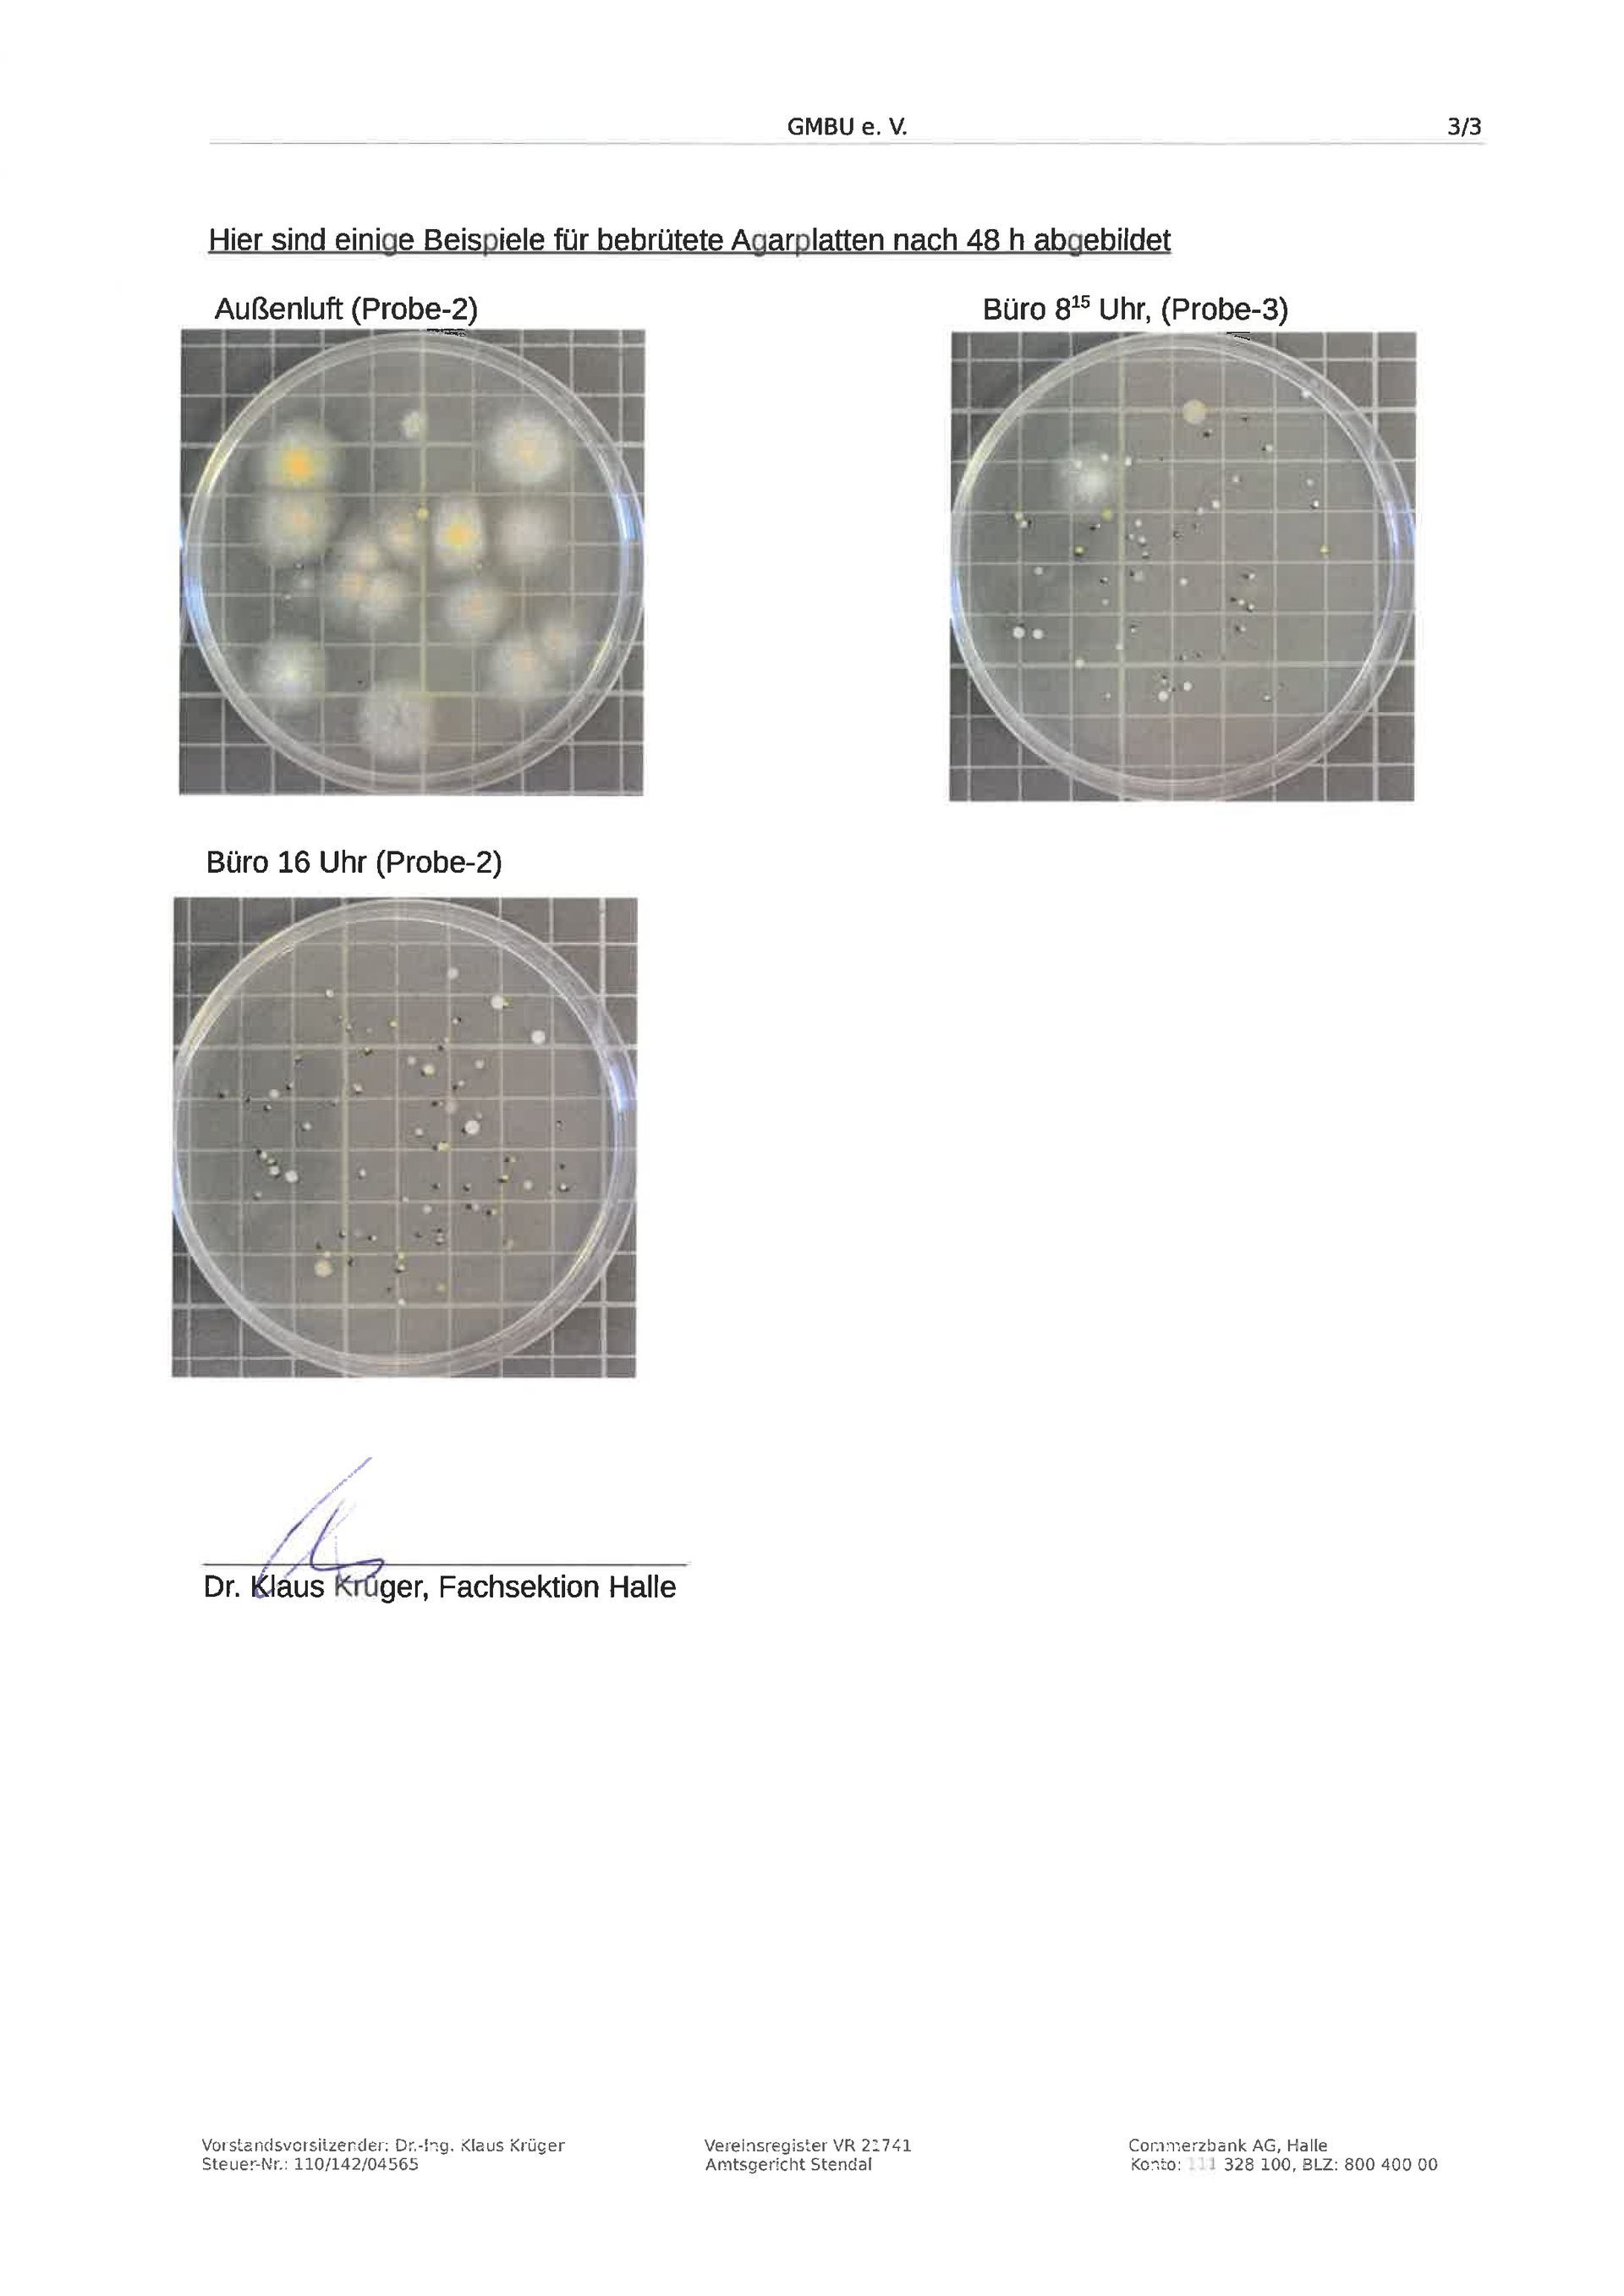

lab report
Read the laboratory report below on the investigation of germ reduction in the room air with the help of our AIRnessi marine air conditioner and ours
AIRbound-Sole.
With the AIRbound room air system, the germ load in the air is demonstrably reduced by up to 87%.
Find out more about the AIRbound room air system and our advantages.